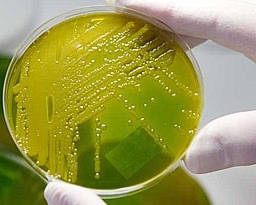

Спецслужбы Великобритании назвали новую причину появления микроорганизма E.сoli, вызвавшего массовые отравления в Европе.
Эксперты британского Центра защиты национальной инфраструктуры предполагают, что распространение опасной бактерии в Германии и других странах Европы могло быть преднамеренным.
"Есть вероятность, что это какой-то ненормальный, который думает: "Убью пару человек, а другие 10 000 пусть страдают от диареи". Было бы большой ошибкой не провести расследование и в этом направлении", - заявил немецкий врач, заведующий по гигиене клиник Vivantes Клаус-Дитер Цастров.
Цастров подчеркнул, что бактерия вполне могла быть создана по заказу террористических организаций. Тот факт, что речь идет о совершенно новом микроорганизме, до этого не известном человечеству, наводит на мысль о его искусственном происхождении.
Британские службы безопасности не исключают, что к делу могли приложить руку такие экстремистские группировки, как "Аль-Каида", Ирландская республиканская армия и борцы за права животных.
На данный момент отравления неизвестной кишечной бактерией зафиксированы в Германии и нескольких соседних странах.
В воскресенье было выявлено несколько новых случаев в Финляндии и Италии.
Всего в Европе от смертельной кишечной инфекции погибли 25 человек, тысячи госпитализированы.
Ожидается, что число жертв будет неуклонно расти.
Комментарии